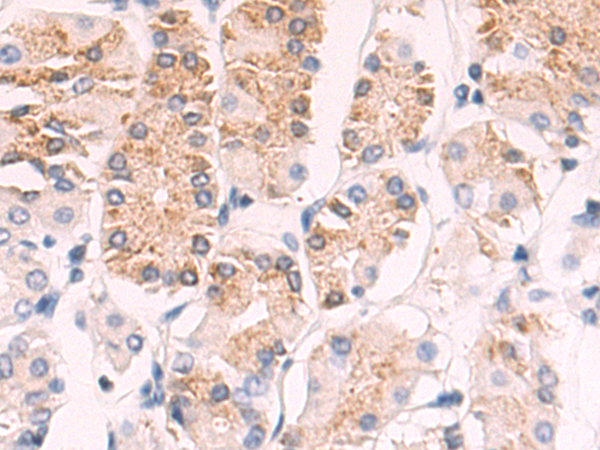

别名:应用:IHC
反应种属:Human
规格:50μl/100μl
| Description |
|---|
| Cholesterol homeostasis is regulated, at least in part, by sterol regulatory element (SRE)-binding proteins (e.g., SREBP1; MIM 184756) and by liver X receptors (e.g., LXRA; MIM 602423). Upon sterol depletion, LXRs are inactive and SREBPs are cleaved, after which they bind promoter SREs and activate genes involved in cholesterol biosynthesis and uptake. Sterol transport is mediated by vesicles or by soluble protein carriers, such as steroidogenic acute regulatory protein (STAR; MIM 600617). STAR is homologous to a family of proteins containing a 200- to 210-amino acid STAR-related lipid transfer (START) domain, including STARD4. |
| Specification | |
|---|---|
| Swissprot | Q96DR4 |
| Host/Isotype | Rabbit IgG |
| Storage | Store at 4°C short term. Aliquot and store at -20°C long term. Avoid freeze/thaw cycles. |
| Species Reactivity | Human |
| Immunogen | Synthetic peptide of human STARD4 |
| Formulation | pH7.4 PBS, 0.05% NaN3, 40% Glycerol |
| Application | |
|---|---|
| IHC | 1/50-1/200 |
| ELISA | 1/5000-1/10000 |
![]() |
The image is immunohistochemistry of paraffin-embedded Human colorectal cancer tissue using P05366(STARD4 Antibody) at dilution 1/50. (Original magnification: ×200) |
![]() |
The image is immunohistochemistry of paraffin-embedded Human gastric cancer tissue using P05366(STARD4 Antibody) at dilution 1/50. (Original magnification: ×200) |
本公司的所有产品仅用于科学研究或者工业应用等非医疗目的,不可用于人类或动物的临床诊断或治疗,非药用,非食用。
暂无评论
本公司的所有产品仅用于科学研究或者工业应用等非医疗目的,不可用于人类或动物的临床诊断或治疗,非药用,非食用。
中文

发表回复